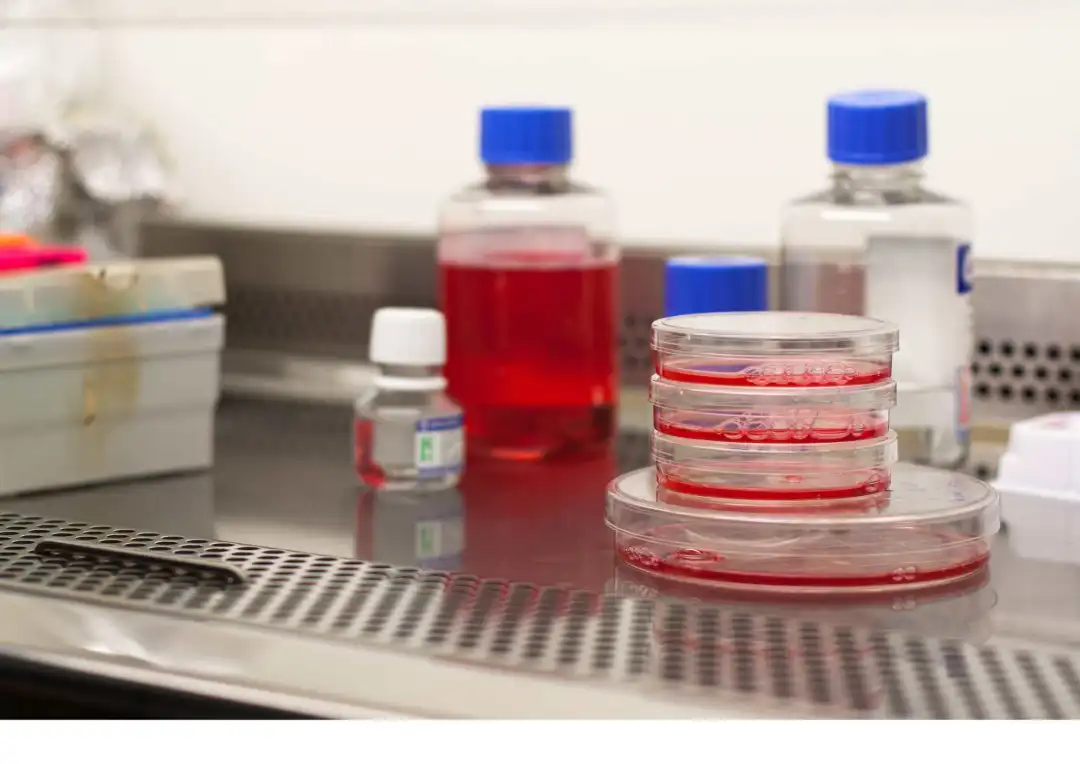

2025年诺贝尔生理学或医学奖让免疫学研究成为全球焦点,三位科学家在调节性T细胞领域的突破性发现,为理解自身免疫性疾病和癌症治疗开辟了新路径。
在众多关于免疫学突破的报道中,有一个细节常被忽略:这些颠覆性的生命科学研究,都离不开一个严格受控的洁净实验环境。
研发离不开对环境的极致追求
这类细胞的培养和操作需要在高纯无菌环境中进行,任何微小的污染都可能影响细胞的活性和功能,进而改变实验结果的可靠性。科研人员不仅要确保细胞的高存活率,还要维持培养环境的稳定性,实验环境是一项严苛的挑战。
提供可靠的洁净环境的手套箱
在生物医学研究中,许多实验材料对水分、氧气都极为敏感。我们为生物医学行业提供了可靠的环境控制解决方案。

1.设备洁净度等级可选(ISO2级、Class 10级、Class100级),满足不同生产要求。集成灭菌系统,有效降低箱体内的生物负荷。
2.部分实验室需湿度控制 ,我们可定制外接雾化与集成加湿系统。 调节范围1-90%RH或1ppm-50ppm 满足精准需求。 配液体高效回收装置, 实现废液再利用 保障稳定提资源回收率,结合干燥压缩气循环控湿 。为湿度敏感实验提供定制方案。

3.我们发洁净手套箱水氧含量控制在<1ppm,泄漏率低至0.001vol%/h,有效防止实验品对人员与环境造成伤害,有效地保障了科研人员的生命健康。为细胞培养、试剂保存等关键环节提供可靠的保护屏障。

4.操作全程在高密闭的箱体内完成,让生产实验的纯净程度更上一层楼,从而降低实验风险。


在前沿技术不断发展的今天,制造业日益高呼的高效性、高韧性的生产运营模式也面临着更高的要求。 虽然我们未曾直接为诺奖得主的实验室提供服务,我们,我们一直致力于实现经济高效、简单操作、可靠稳定的惰性气氛解决方案,从而能为各行业带来智能生产力的进一步解放。